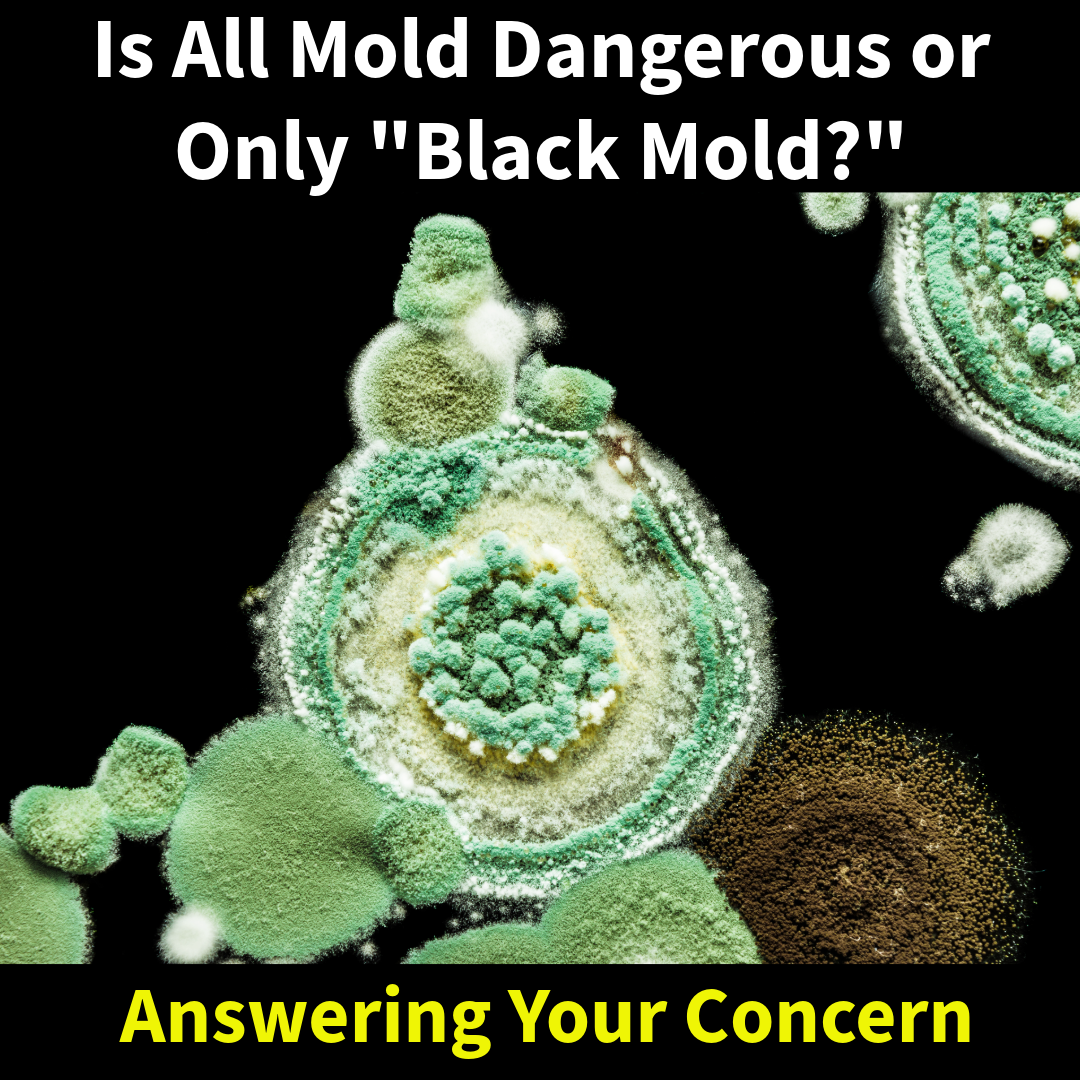

Our
Response Time
24 Hour Emergency Service
After you have scheduled your remediation service with us, this is what you can expect on the day we arrive.
When most people think about mold, they immediately think of “black mold” and assume it is the only...

When water damage occurs in a home, one of the most common questions homeowners ask is how quickly...

Recently we were contacted by homeowners who had just purchased a property in Haverford, Pennsylvania. During the home...